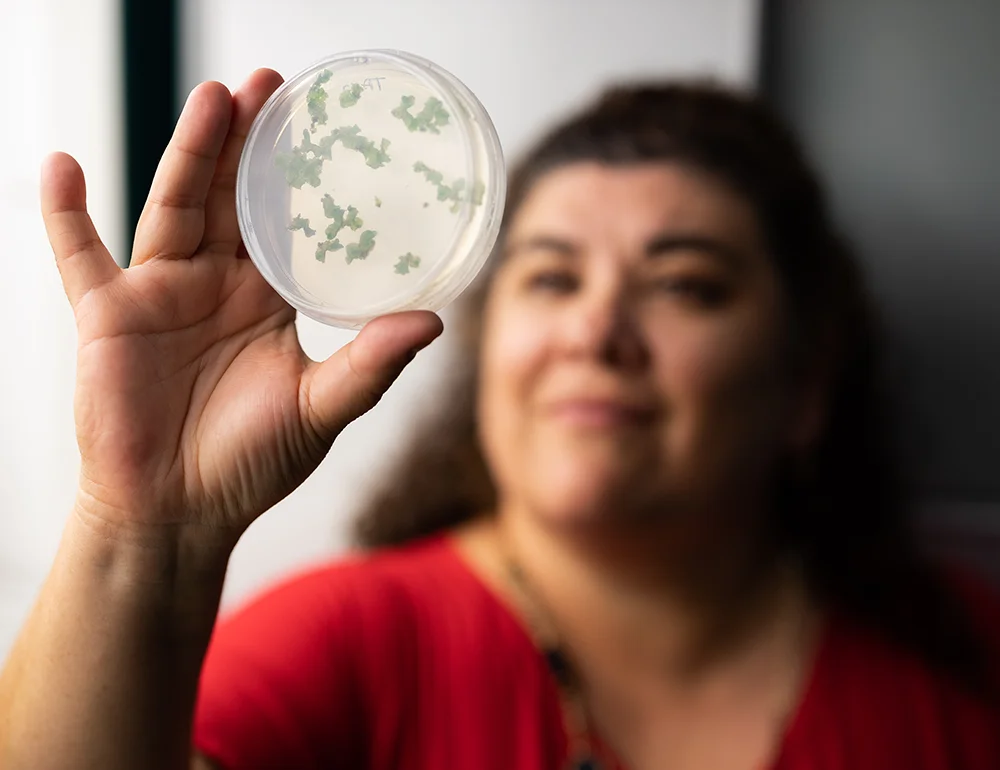
A woman holding up a petri dish containing leaves.

BSA in Plant and Soil Science

Grow your future from the ground up with a B.S.A. in Plant and Soil Science at A-State. Our program gives you the skills to lead in modern agriculture and sustainable land management. You'll study everything from crop production and horticulture to soil science and precision ag technologies. We also offer two emphasis areas: Agronomy, focused on crops and field systems, or Environmental Horticulture, where plant science meets landscape and greenhouse management.

Degree Overview
BSA in Plant and Soil Science
Throughout your degree, you'll gain valuable hands-on experience through research projects and lab work. Our dedicated faculty are not only experts in plant and soil science; they're passionate mentors who are here to help you grow your skills and achieve your goals. From developing management strategies to solving real-world challenges, you'll be prepared to lead the future of agriculture and land stewardship from day one after graduation.
College
College of AgricultureCost
Tuition & FeesAdmission Requirements
- 3.0 GPA
- 2.0 for transferring students
- Completed Online Application
-
Application Fee: $30
- Official Transcripts
- Immunization Record
Careers & outcomes
What can I do with a Plant and Soil Science degree?
We give you the tools to tackle real challenges after graduation. Explore careers as a:
- Crop and Soil Scientist
- Soil Technician
- Environmental Scientist
- Hydrologist
- Crop Consultant
Connect With Us.
Program Requirements
FRESHMEN STUDENTS
Freshmen applicants who meet one of the following criteria will receive automatic admission to Arkansas State. While you have to meet minimum criteria, test scores are still required:
- 3.00 cumulative high school grade point average (or GED test score equivalent)
- 19 minimum ACT super score or minimum 990 combined SAT super score
- Class rank in the top 20% of applicant's graduating class
- A holistic application review process
Admitted freshmen who require remediation (based on entrance exam scores) or who have less than a 3.00 cumulative high school GPA will be required to participate in the Transition Studies leadership based support program throughout their enrollment at Arkansas State University
ADMISSION APPEALS
Freshmen applicants who do not meet automatic admission standards may be admitted to the university upon approval of the Undergraduate Admissions Appeal Committee. Freshmen approved by the Undergraduate Admissions Appeal Committee will participate in the Transition Studies leadership-based support program. In addition to an official high school transcript and official entrance exam scores, submit to the committee:
- Two letters of recommendation
- Statement of purpose answering the following prompts:
- Why is A-State a good fit for you and your educational goals?
- What are your academic and personal strengths and how do you plan to grow as a student at A-State?
- What experiences outside of the classroom impact or had an impact on your academic performance.
Documents must be submitted at least two weeks before the start of classes for the semester.
FRESHMAN ADMISSION CHECKLIST:
- Completed Online Application
- $30 Application Fee
- Official High School Transcript
- Official ACT/SAT Score
- Immunization Record (2 MMRs)
TRANSFER STUDENTS
ADMISSION CRITERIA:
Transfer students are encouraged to apply for admissions the semester prior to enrolling
in classes. You must have a cumulative 2.0 GPA on ALL transfer work. Students still
in high school who have earned college credit should apply as a freshman.
TRANSFER ADMISSION CHECKLIST:
- Completed Online Application
- $30 Application Fee
- Official college transcript(s) from all colleges attended (emailed attachments and faxes will not be accepted)
- Completion of English Comp I and College Algebra OR official entrance exam scores
- Immunization Record (2 MMRs)
NON-DEGREE STUDENTS
ADMISSION CRITERIA:
Individuals who wish to pursue courses of special interest without submitting academic
credentials may register for a maximum of six hours per semester (or three per summer
term) accumulating up to 12 semester hours of undergraduate non-degree credit. Thereafter,
non-degree students must comply with university admissions requirements or obtain
a written waiver from the Registrar.
CAUTION: Non-degree students should not enroll in courses that are required in the general education program. Courses taken for non-degree credit are not acceptable toward a degree unless validated later by the student's meeting all conditions for admission to the university, including remediation requirements.
Non-degree students are required to meet the same course prerequisites as other students. Non-degree students are generally not eligible to participate in financial aid programs. Due to specific enrollment limitations, non-degree students may not register through the university's web registration system.
NON-DEGREE ADMISSION CHECKLIST:
- Completed Online Application
- $30 Application Fee
- Immunization Record (2 MMRs)
POST-DEGREE STUDENTS
ADMISSION CRITERIA:
Students who have earned a bachelor's degree and plan to enroll in additional undergraduate
coursework should apply as a post-degree student. This includes students who earned
a bachelor's degree at A-State.
POST-DEGREE ADMISSION CHECKLIST:
- Completed Online Application
- $30 Application Fee
- Official college transcript where the bachelor's degree was received
- Immunization Record (2 MMRs)
RETURNING (READMIT) STUDENTS
ADMISSION CRITERIA:
Students who have previously attended A-State but have not completed a bachelor's
degree should apply as a readmit student. If you earned credit at A-State while still
in high school, you should apply as a freshman or transfer student. Students who attended
A-State and then attended another college should apply as a readmit student and submit
the transcript from another institution.
RETURNING ADMISSION CHECKLIST:
- Completed Online Application
- $30 Application Fee
- Completion of English Comp I and College Algebra OR entrance exam scores
- Official College Transcript (If attended another institution after you attended A-State)
- Immunization Record (2 MMRs)
TRANSIENT STUDENTS
ADMISSION CRITERIA:
Students who have not earned a bachelor's degree who are enrolled at another institution
and plan to transfer coursework back to their home institution should apply as a transient
student. Transient students are required to meet the same course prerequisites as
other students. Transient students are not eligible for financial aid or scholarships.
TRANSIENT ADMISSION CHECKLIST:
- Completed Online Application
- $30 Application Fee
- Official college transcript from currently enrolled college or letter of good standing
- Immunization Record (2 MMRs)
CONCURRENT STUDENTS
The A-State Concurrent Program is a partnership between the university and high schools to offer qualified high school students the opportunity to satisfy both high school and university credit requirements simultaneously through specific concurrent credit courses.
1. TAKE A CAMPUS TOUR
Learn about all A-State has to offer while visiting campus! We have a great team of student Chancellor's Ambassadors who love showing future students around the place they call home. To schedule a campus visit, click the link below and select the type of tour, date, and time that works best for you.
2. COMPLETE AN APPLICATION FOR ADMISSION
Please complete an online admissions application. Click the link "Create an account" under the First-Time User heading. You will be emailed a temporary PIN number for your initial log in. Then you can set a new password. This will allow you to log in at any time and check your application status. For more detailed instructions, please check our UG application guide.
Go to the online application >>
3. SUBMIT A $30 NON-REFUNDABLE APPLICATION FEE
You will pay the application fee online when completing your application. To apply for an application fee waiver, please submit the Undergraduate Application Fee Waiver Request Form.
4. REQUEST OFFICIAL TRANSCRIPT
Once you've applied, have your high school send us your transcript. This is typically handled through your high school counseling office. Also, if you've taken any concurrent enrollment college courses, have those official transcripts sent as well.
Official transcripts can be sent electronically through school-verified sites or mailed to:
Office of Admissions, Records and Registration - Arkansas State University
P.O. Box 1800
State University, AR 72467
5. SEND OFFICIAL TEST SCORES
Prospective students may use the following submission methods:
- High School Transcripts and Test Scores:
All high school transcripts, ACT scores, and SAT scores must be sent directly from the high school or issuing institution, either via mail or electronically, to be considered official.
Examples of school-verified electronic sources:- TRIAND
- EDI
- eScript
- Scoir
- Slate.org
- Parchment
Office of Admissions - Arkansas State University
P.O. Box 1800 | State University, AR 72467
If a student hand-delivers a transcript or test scores, they must be in a sealed envelope from the institution to be considered official. - College Transcripts and Test Scores:
All college transcripts must be sent directly from the institution via mail or electronically to be considered official.
Accuplacer scores must come directly from the institution or College Board to be considered official.
If a student hand-delivers transcripts or test scores, they must be in a sealed envelope from the institution to be considered official. - Documents Received by A-State Admissions Counselors:
Transcripts, test scores and shot records received by A-State Admissions Counselors during school visits should be uploaded directly into Slate. These documents are considered official if:- They are received directly from a school official.
- They are received from the student in a sealed, school-branded envelope.
- The Admissions Counselor who receives these documents must attest to their authenticity.
- Proof of MMR Immunization:
Students may submit proof of MMR (Measles, Mumps, Rubella) immunization directly. These documents are not required to be in a sealed envelope. - Official Test Scores:
ACT Scores:
ACT scores can be sent directly to Arkansas State University via the high school or through Encoura. For more information on how to send ACT scores, visit ACT Score Sending.
SAT Scores:
SAT scores can be sent directly via the high school or through the College Board. For details on sending SAT scores, please refer to SAT Score Sending.
Accuplacer Scores:
Accuplacer scores can be sent directly by the testing administrator at the testing site, the College Board, or through the A-State Testing Center. For more information, visit Accuplacer Score Information.
6. SUBMIT TWO MMR (MUMPS, RUBELLA & RUBEOLA/MEASLES) RECORDS
MMR records are not required for admissions but must be submitted to enroll in on-campus courses.
Upload a copy of your MMR records to your application or have MMR records sent to:
Office of Admissions, Records and Registration - Arkansas State University
P.O. Box 1800

